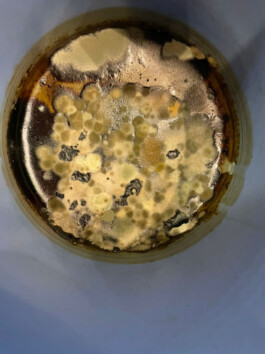
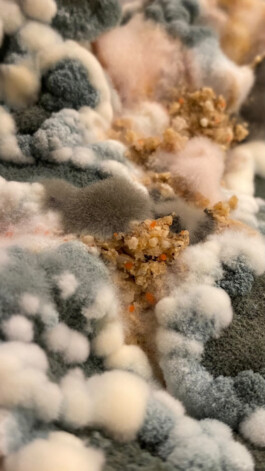
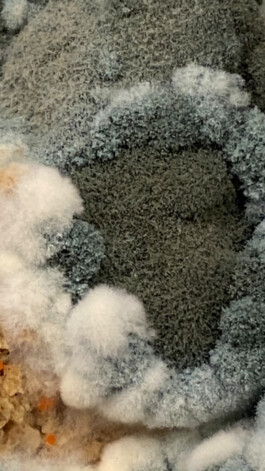

déjalo (mor)ir: aborda el vínculo entre la vida y la muerte. Ese vínculo vicioso, íntimo y continuo. Es lo que sucede cuando la belleza muere y deja nacer una nueva forma de preciosura.
Es el punto de partida de las obras a producir: creación de hábitats ideales para que se germinen colonias de hongos en distintos elementos naturales. La idea es estimular la putrefacción para que den lugar a los rastros y patrones de colores producidos por distintas especies de hongos.
Procesos.
Primera etapa: dejar (mor)ir especies para que nazcan sus colonias de hongos.
Segunda etapa: período de registro, investigación y estudio de los patrones de crecimientos de los hongos provenientes de la etapa uno
tercera etapa: armado de plantillas de dibujo. Consiste en la decodificación de los patrones de los hongos en módulos para poder generar las composiciones.
Cuarta etapa: dibujo en tinta china y plumas sobre los papeles vegetales y/o de arroz de las plantillas de dibujo.
La siguiente secuencia de imágenes consiste en un registro fotográfico de los procesos de germinación de los distintos sujetos.